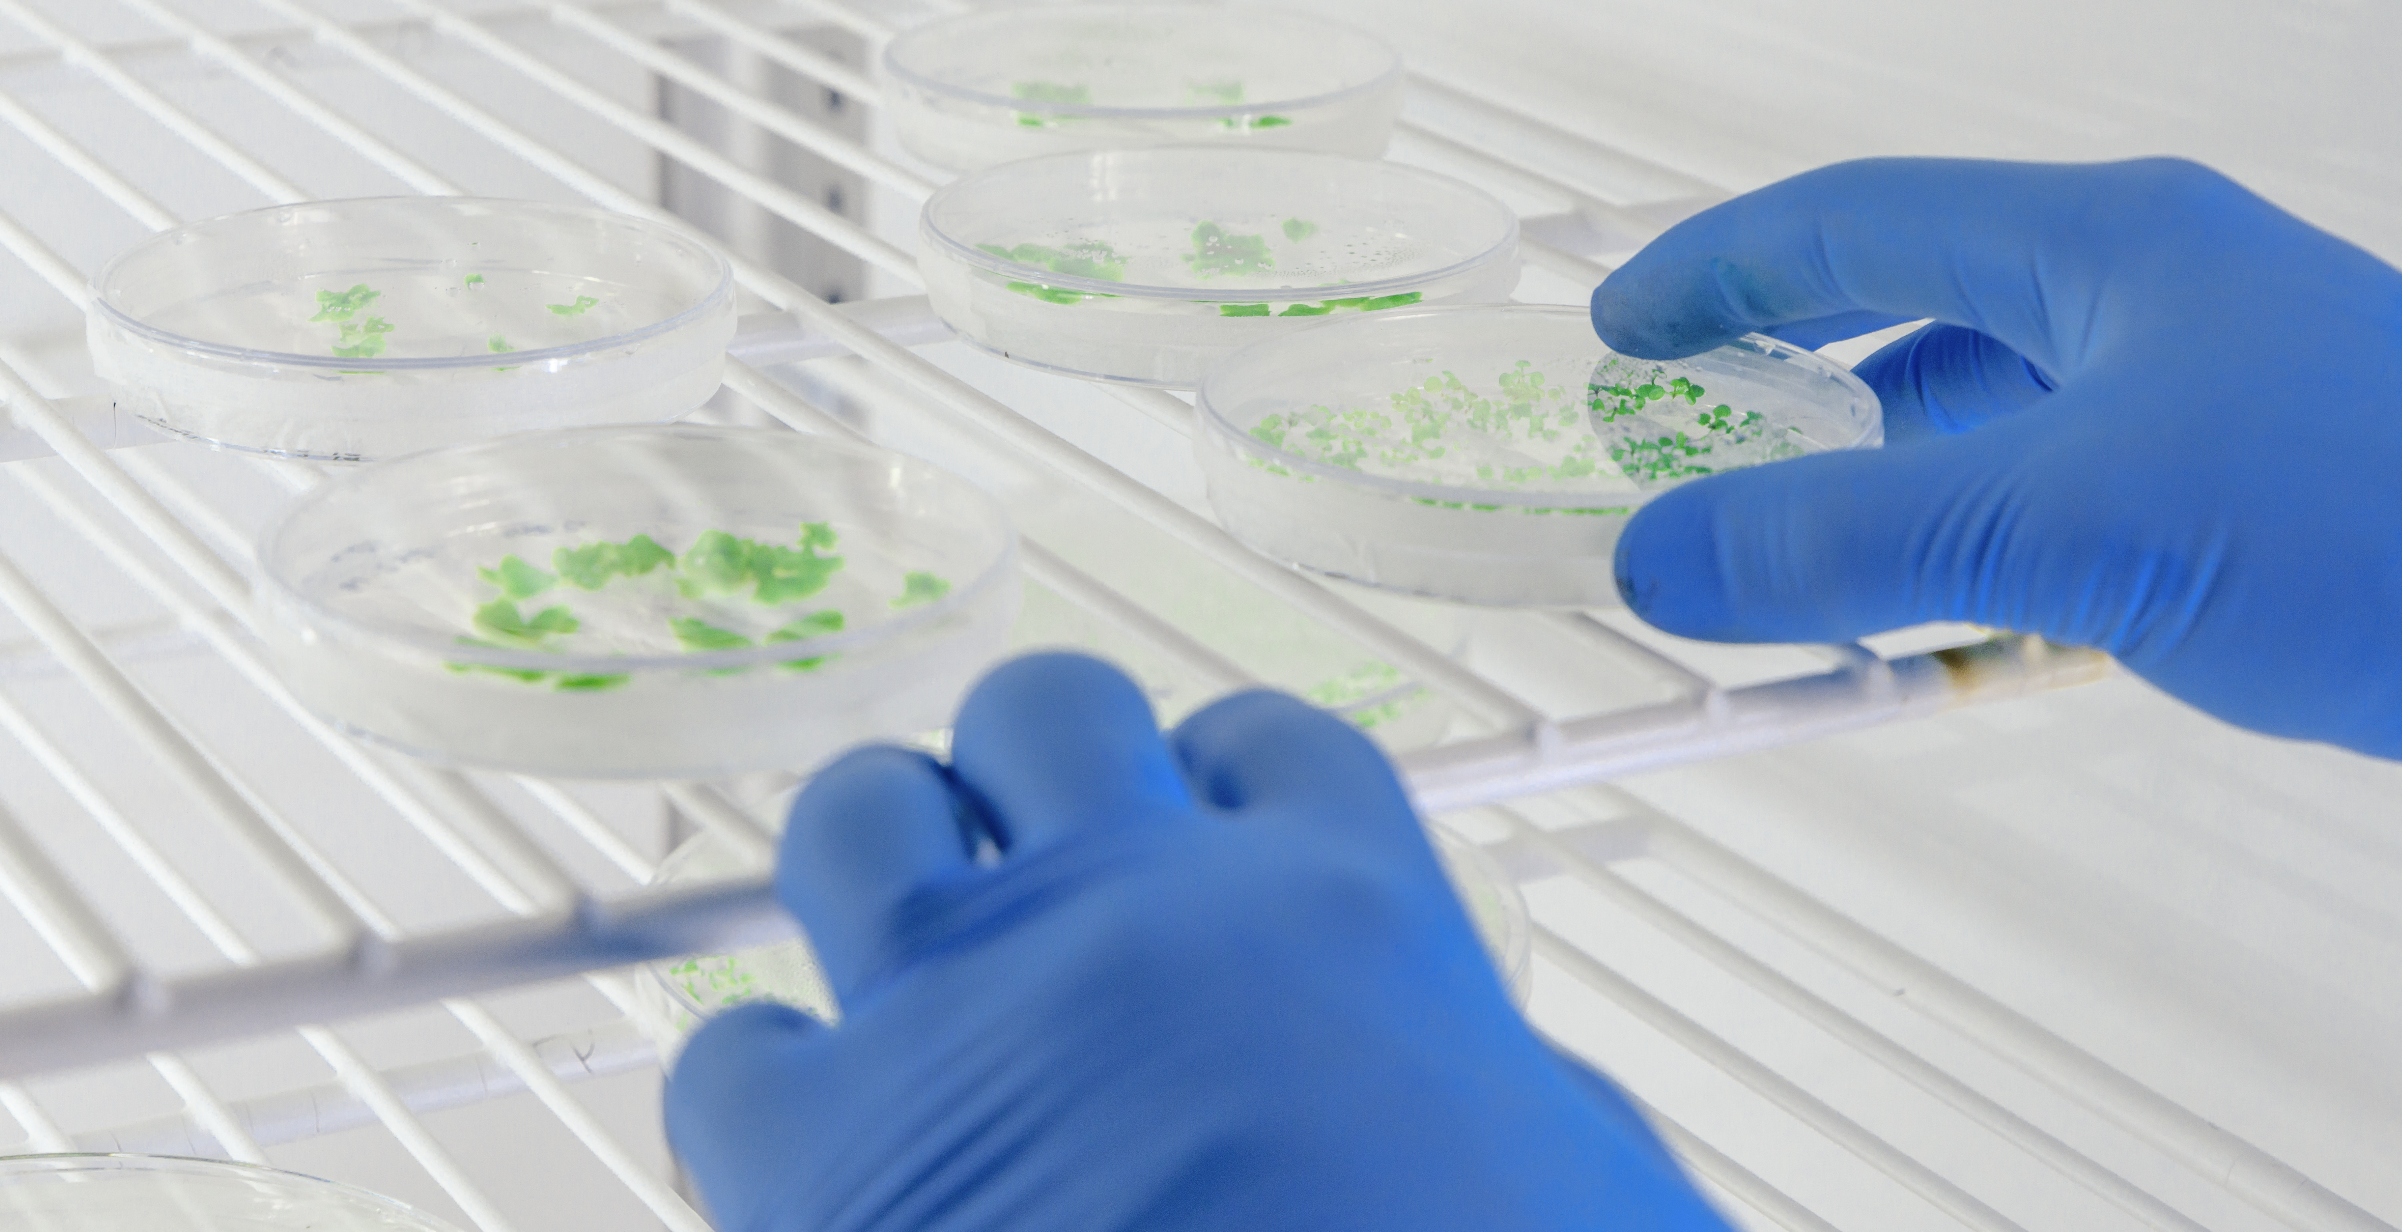

Digital Jounal

Frontiers of BioScience Issue N.1 (Mai, 2025)
From Collapse to Control - How Precision Biotechnology and Probiotics Could Redefine the Post-Antibiotic Era
digital journal
Frontiers of BioScience Issue N.2 (Jun, 2025)
Microbiota, Immunity and Neuroplasticity - The Forgotten Triad of Modern Mental Health
digital journal
Frontiers of BioScience Issue N.3 (Jun, 2025)
Redesigning Psychiatry - The new era of biotechnology, the microbiome, and translational neuroscience
digital journal